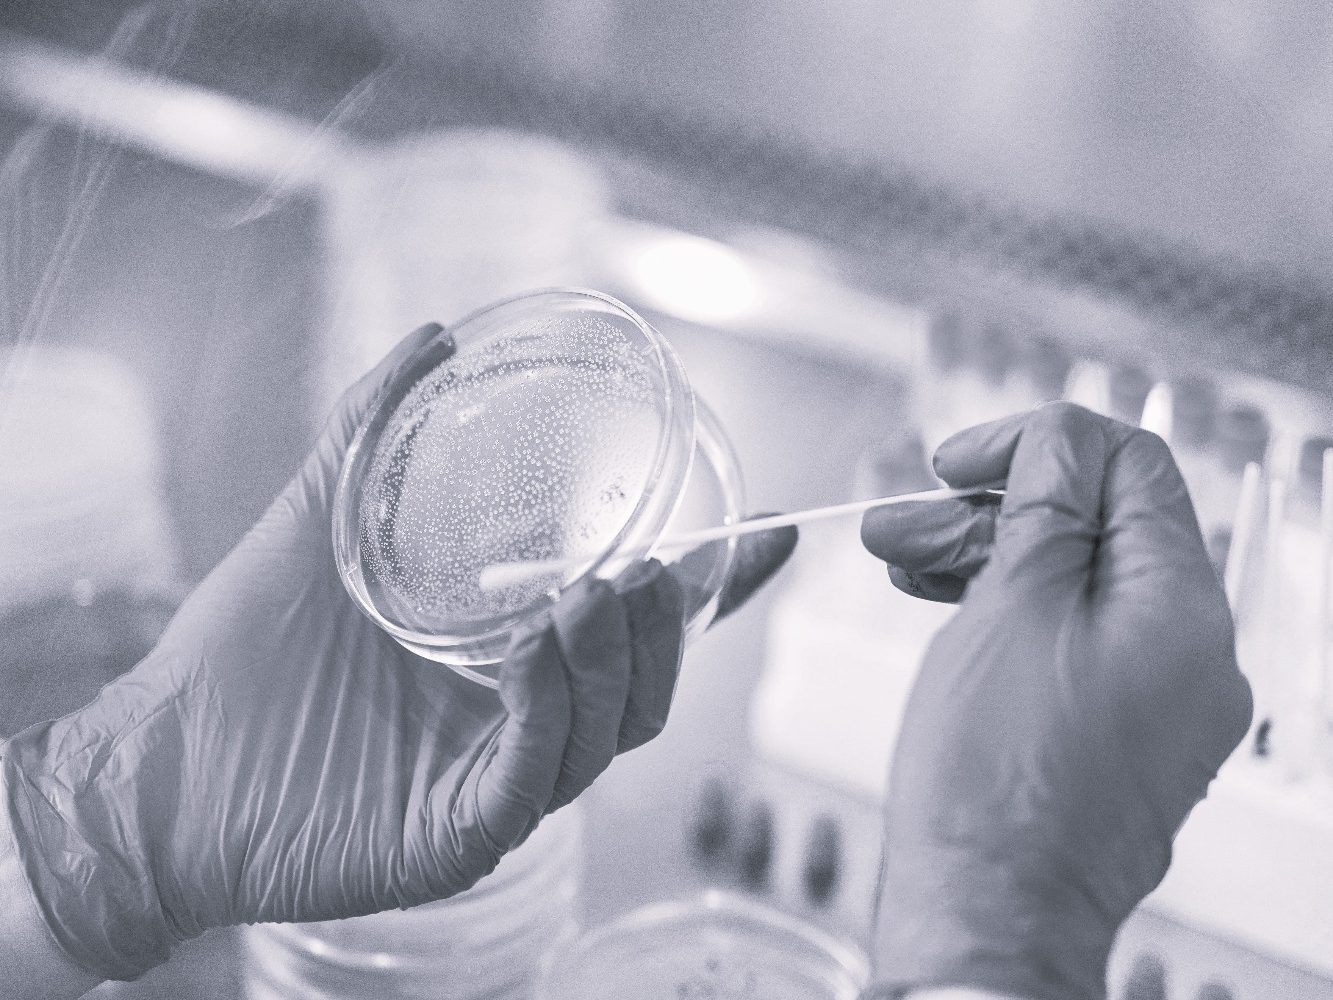

Sachverstand GbR
Wir bieten umfassende Sachverständigentätigkeiten im Bereich Schimmelpilzbefall und damit verbundene Bauschäden.
Hierzu zählen die Ursachenermittlung, die Bewertung von dem Pilz und seinen Auswirkungen sowie eine Anleitung zur Lösung des
Problems.
Vertrauen Sie auf unsere Expertise!
Ihr Partner für
Begehungsprotokolle & Gutachten
Als Dekra zertifizierte Sachverständige im Bereich Schimmelpilzbewertung und damit verbundene Bauschäden stehen wir Ihnen mit unserer Erfahrung zur Seite.
Wir erkennen und beurteilen Schimmelpilz- und die dadurch entstandene Folgeschäden an Bauteilen.
Ob eine Vor-Ort-Begutachtung, eine
gutachterliche Beurteilung oder ein
umfangreiches Gutachten: wir sind Ihr qualifizierter Ansprechpartner!

13
Jahre Erfahrung im Bereich
Schimmelsanierung
zahlreiche
Begehungsprotokolle & Gutachten
Für Privatpersonen
(Eigentümer und Mieter),
Hausverwaltungen &
Versicherungen

Schimmelpilze und ihre Auswirkungen
In den letzten Jahren haben Allergien und ähnliche Erkrankungen stetig zugenommen. Obwohl viele Untersuchungen durchgeführt und Verbesserungen erreicht wurden, ist der Trend, wonach sich die Anzahl der Allergieerkrankungen etwa alle 10 bis 15 Jahre verdoppelt, immer noch ungebrochen.
Alleine in Deutschland ist die Zahl der Allergiker auf über 30 Millionen Mitbürger angestiegen, wovon allein circa 30% von einer Schimmelpilzallergie betroffen sind, dicht gefolgt mit 20% Hausstaub- und Milbenallergien.
Ursachenermittlung
Oftmals entwickeln sich Schimmelpilze im Verborgenen. Sie werden deshalb als mögliche Ursache von gesundheitlichen Beschwerden - die sehr verschieden sein können - von den Bewohnern und Benutzern nicht in Betracht gezogen.
Wir helfen Ihnen die Ursachen zu ermitteln:
Wasserschaden (verdeckt oder offensichtlich), bauliche Mängel, ungeeignetes Wohnverhalten...
Die Gründe für Schimmel in den eigenen vier Wänden sind vielseitig, das Ziel unserer Arbeit ist jedoch eindeutig:
ein Leben ohne Schimmelpilzbefall!

Probenentnahme
In manchen Fällen ist es notwendig, nicht nur die Ursache zu kennen, sondern auch die Schimmelpilze zu identifizieren.
Durch die Zusammenarbeit mit Laboren können wir Ihnen mit Hilfe von unterschiedlichen Probenentnahmeverfahren ein genaues Bild von dem unerwünschten Gast liefern und anschließend die
notwendige Sanierung darauf abstimmen.
Unser Komplettpaket für Sie
Wir bieten Ihnen eine professionelle Beratung und Unterstützung bei der Beseitigung von Schimmelpilzen und deren Auswirkung auf die Bausubstanz.
Durch unser Netzwerk können wir Ihnen das Rundum-Sorglos-Paket anbieten: die Ursachenermittlung, die Bewertung, sowie die Anleitung und Ausführung der Sanierungsmaßnahme.


Wer wir sind
Simone Niesen:
staatlich geprüfte Gestalterin, Malermeisterin, Dekra zertifizierte Sachverständige für Schimmelpilzbewertung, Dekra zertifizierte Fachkraft für Schimmelpilzbeseitigung
Marco Meuser:
Altgeselle im Malerhandwerk, Fachkaufmann, Dekra zertifizierter Sachverständiger für Schimmelpilzbewertung, Dekra zertifizierte Fachkraft für Schimmelpilzbeseitigung
Wir bieten Ihnen:
Vor-Ort-Begutachtung
- persönliche Beratung bei einem Vor-Ort-Termin
- mündliche Beurteilung der baulichen und häuslichen Gegebenheiten
- Messungen: Raumtemperatur, Oberflächentemperatur, relative Luftfeuchte, Materialfeuchte, Referenzmessungen
- mündliche Ratschläge zur Vermeidung weiterer Schäden und Vorschläge zur sofortigen Wiederherstellung
- die schriftliche Ausführung beinhaltet: stichpunktartig die Ursache sowie die Empfehlung zur Behebung
- bei Bedarf erhalten Sie ein Hand-out zum Thema "Richtig Heizen und Lüften"
ab 200,00 € netto
Gutachterliche Beurteilung
- persönliche Beratung bei einem einstündigen Vor-Ort-Termin
- mündliche Beurteilung der baulichen und häuslichen Gegebenheiten
- Messungen: Raumtemperatur, Oberflächentemperatur, relative Luftfeuchte, Materialfeuchte, Referenzmessungen
- mündliche Ratschläge zur Vermeidung weiterer Schäden und Vorschläge zur sofortigen Wiederherstellung
- die schriftliche Ausführung beinhaltet: örtliche Gegebenheiten, sämtliche Messdaten sowie die verwendeten Messgeräte, Ursache(n), Anweisung zur Behebung und zukünftigen Vermeidung von neuem Befall, bei Bedarf der Wegweiser zum Thema "Richtig Heizen und Lüften"
ab 474,00 € netto
Umfangreiches Gutachten
- persönliche Beratung bei einem einstündigen Vor-Ort-Termin
- mündliche Beurteilung der baulichen und häuslichen Gegebenheiten
- Messungen: Raumtemperatur, Oberflächentemperatur, relative Luftfeuchte, Materialfeuchte, Referenzmessungen
- mündliche Ratschläge zur Vermeidung weiterer Schäden und Vorschläge zur sofortigen Wiederherstellung
- die schriftliche Ausführung beinhaltet: ca. 30 Seiten mit sämtlichen Daten sowie Referenzdaten, einer ausführlichen Darlegung der Messmethoden und -geräte, eine Fotodokumentation, Darstellung allgemein gültiger Optimalwerte als Referenz, Beweissicherung und Dokumentation als Vorlage für gerichtliche Streitigkeiten
ab 854,00 € netto
Kontakt aufnehmen
E-Mail: mail@sachverstand-bauschäden.de